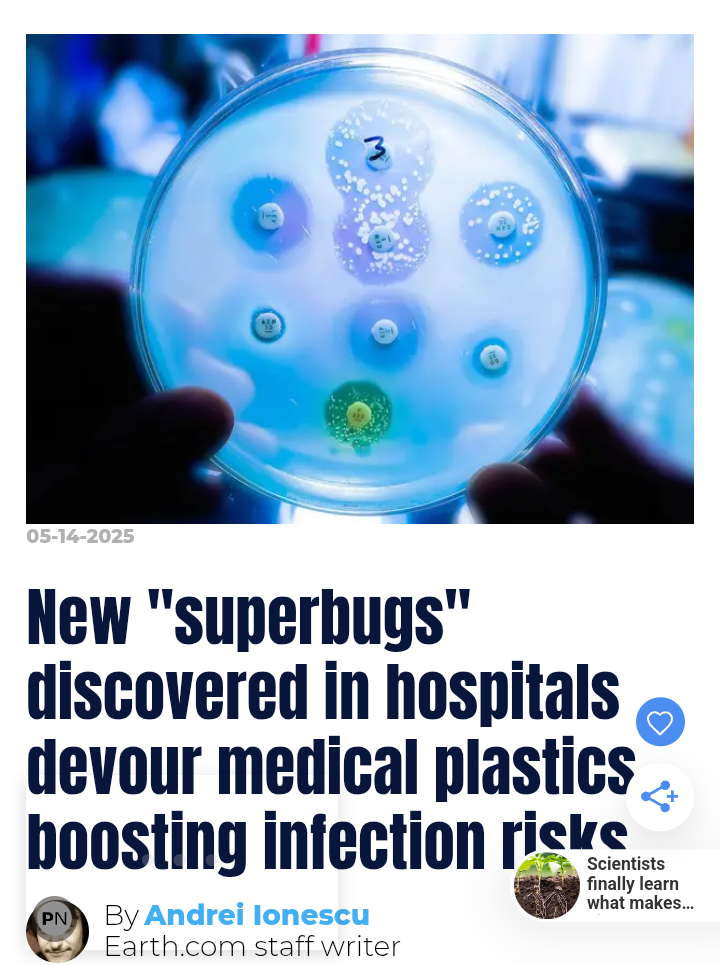
1000113866.png

DVD Disc Rot & Hospital Superbugs
In regards to how long a typical DVD’s life expectancy is, Sony’s official statement is that “A typical DVD disc has an estimated life expectancy of anywhere from 30 to 100 years when properly stored and handled.” That’s a pretty substantial 70-year gap in terms of possibilities, but as we hurtle towards the 30th anniversary of the introduction of DVDs in 1996,(click)
From: Chuck Darling
April 26, 2025
Disc Rot...
It seems all spinnable drive media
suffer from some form of it.
The early hard drives were notorious
for eventual bearing failures,
and head crashes.
Technological obsolescence
is a nagging worry as well ...
LP records and high-fidelity playback
systems are becoming rare.
Cassette tapes ?
Try to find one...
The advent of music CDs seemed
to be a solution, until they stopped
putting CD drives in PC's ...
DVDs seemed like a panacea.
Huge storage capacity, enough
for feature films. Laser playback,
so wear was not a concern.
Until now.
I read this book in the '70s...
It concerned me.
The team traced the plastic-eating trick to a single enzyme, which they named Pap1. In laboratory tests, Pap1 reduced a thin PCL film by seventy-eight percent within seven days. The bacterium then used the liberated fragments as its sole carbon source.
Try plating the film with SILVER... -Chuck
*************
* Back to Rotating Storage...
*************
The Xerox ALTO computer paved the way
for the Apple Macintosh GUI OS.
Watch technicians laboring to recover
data on Xerox disc packs...
Life is a constant struggle...
Even Digital life...
Don't think that it's just DVDs that are affected...
This ring had a resin bezel, it lasted about
two years, then began to show dark spots
around the edges, finally bubbling up.

The curb paint looks attacked, as does
the heavy plastic street marker lines ...
If a bacteria is attacking street paint...
what about tires...?
what about asphalt ?
what about Tarmac ?
What about epoxy laminates ?
What about fabrics ?
What about Shoes ?
What about plastic appliances ?
What about. electrical insulation ?
What about Aircraft controls ?
What about epoxy laminated
computer chips?
... If the package becomes porous...
oxygen and water vapor will enter...
How much oxidation would you need
to harm 2 nanometer chip elements ?
(Intel is going to 2nm architecture...)
House Paints. ?
Roofing Materials ?
Valves ?
3D printed parts ?
Precision Electrical connectors ?
Fast Charger insulation and connectors..
In short, you have a ghastly mess !
[Chuck's 00Cedar JPICedar ]
[ This page built with JPICedar by Chuck Darling Saturday April-26-2025 Time : 12:18pm]
https://archive.ph/